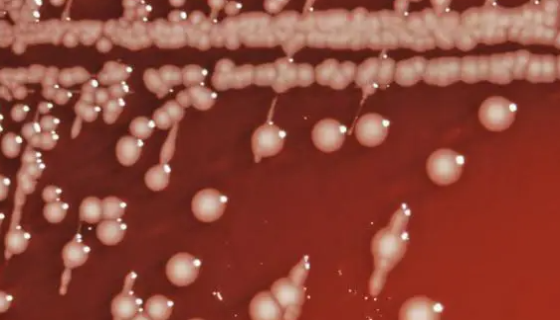
肠沙门氏菌肠亚种猪霍乱血清型冻干管打管说明！

大鼠骨髓间充质干细胞的传代方法及应用!
大鼠骨髓间充质干细胞是从成年大鼠骨髓组织中分离得到的,原代冻...

用于生产食品及食品增色用的——丛毛红曲
丛毛红曲是Monascus属的微生物,原产地为中国。主要用途...
肠沙门氏菌肠亚种猪霍乱血清型冻干管打管说明!
肠沙门氏菌肠亚种猪霍乱血清型,G-杆菌,尿素酶、苯丙氨酸脱氨...

THP-1 人白血病细胞的复苏与传代及其应用!
THP-1人白血病细胞是1980年Tsuchiya等人建立的...

人冠状动脉内皮细胞的培养步骤与应用!
人冠状动脉内皮细胞提取于人心脏组织,提取纯化之后立即冻存。每...

豚鼠气单胞菌的培养条件与注意事项及保藏方法!
豚鼠气单胞菌,属质控菌株,除弯曲菌属需冷冻保存(-18℃)外...

小鼠子宫内膜间质细胞的运输和保存及处理方法!
子宫内膜由粘膜上皮、腺体、间质和血管等组成,是卵巢激素作用的...

气单胞菌属的分类与鉴定及致病性与检测方法!
气单胞菌属为弧菌科(Vi-brio)中的一类革兰氏阴性短杆菌...
